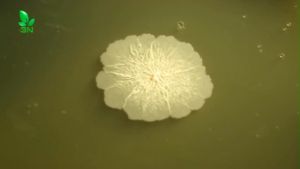
Gói 1 Kg Bacillus Amyloliquefaciens Mật Độ 100 Tỷ CFU/gr Dùng Cho Chăn Nuôi Và Nông Nghiệp

6 cái bong bóng thủy tinh đồ treo trang trí cá các loại cá thủy tinh Charm treo bong bóng Aquarium Float decors
Đắm mình trong sự quyến rũ của các nghệ sĩ thủ công với bộ trang trí nổi bằng kính của chúng tôi, các thiết kế Cá bong bóng độc đáo biến bất kỳ không gian nào Thành tưởng tượng dưới nước. Mỗi là thủ công tỉ mỉ từ kính chất lượng, tự hào với màu sắc tươi sáng và exceptionals clarities. Thích hợp cho những người đam mê trang trí nhà seekings một liên lạc của sự sáng tạo, những kiểu dáng làm cho một món quà chu đáo cho bạn bè và gia đình, tăng cường niềm vui của dịp. 6 cái bong bóng thủy tinh đồ treo trang trí cá, các loại cá thủy tinh Charm treo bong bóng, Aquarium Float decors. Các tính năng: đắm mình trong sự quyến rũ của nghệ sĩ thủ công với kính của chúng tôi nổi decors thiết lập, featurings thiết kế Cá bong bóng độc đáo mà biến bất kỳ không gian vào tưởng tượng dưới nước. Mỗi là thủ công tỉ mỉ từ kính chất lượng, tự hào với màu sắc tươi sáng và exceptionals clarities. Thích hợp cho những người đam mê trang trí nhà seekings một liên lạc của sự sáng tạo, những kiểu dáng làm cho một mó

Urban Living1
Đánh giá

Có thể bạn cũng thích

Pate KitCat Petite Pouch 70g dành cho mèo dinh dưỡng thơm ngon tăng cường sức khỏe (hàng NK Thái Lan)

Thảm Rải Cát Cho Mèo IRIS Alice Thảm Chống Trượt Cho Thú Cưng Chống Văng Chống Trượt Thảm Chân Mèo Thảm Vệ Sinh Cho Thú Cưng

Máy mài móng cho chó mèo hình dấu chân cổng sạc USB - Love Pets Shop

Chai UV-CEFEN SỐT Bỏ Ăn Không Rõ Nguyên NhânViêm Da Nổi Cục Cho Thú Cưng

Cạ massage có catnip viên kèm lông vũ vui nhộn - Đồ chơi cho mèo - Tiệm Mèo Moa

CHÂN SẮT ĐEN CHO BỂ CÁ 60x40cm CAO 60CM SẮT 3 VUÔNG
![[ CHÍNH HÃNG ] Gel Dinh Dưỡng NUVITA GEL Cho CHÓ MÈO - 120g](https://img.lazcdn.com/g/ff/kf/S4bdb5f8dc473445fbe43ee0e7a0b06fal.jpg_300x300q80.jpg)
[ CHÍNH HÃNG ] Gel Dinh Dưỡng NUVITA GEL Cho CHÓ MÈO - 120g

Vật Nuôi bình đựng tro hỏa Táng Với Nhựa Thiên Thần Decors Bức Tượng túi lưu trữ Cho Chó Và Mèo Tro Container Hộp đồ cho thú cưng

FMSRZX Oxford Túi xách du lịch ngoài trời cho chó Thoáng khí Không gian rộng Túi đeo vai hình mèo Túi mang thú cưng Cầm tay Túi xách đi chơi cho cún con Bốn mùa
![[ 10 lọX 5ml]B12-ATP Asta Tăng thể lực cho ngựa đua gà chọi chó nghiệp vụ.](https://img.lazcdn.com/collect/social-img/7243aff664e84f71a836471c52da091b_08A85778611A46989AFE0996E767D776.jpg_300x300q80.jpg)
[ 10 lọX 5ml]B12-ATP Asta Tăng thể lực cho ngựa đua gà chọi chó nghiệp vụ.
Gói 1 Kg Bacillus Amyloliquefaciens Mật Độ 100 Tỷ CFU/gr Dùng Cho Chăn Nuôi Và Nông Nghiệp



